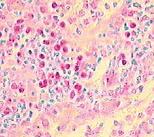

Verde metile pironina - kit
Metodo indicato per la contemporanea visualizzazione del DNA e RNA su sezioni istologiche. Particolarmente indicato per evidenziare plasmacellule ed RNA in sezioni istologiche e preparati citologici
1 Kit - 100 Test
Per accedere a queste informazioni per favore effettua il login o registrati